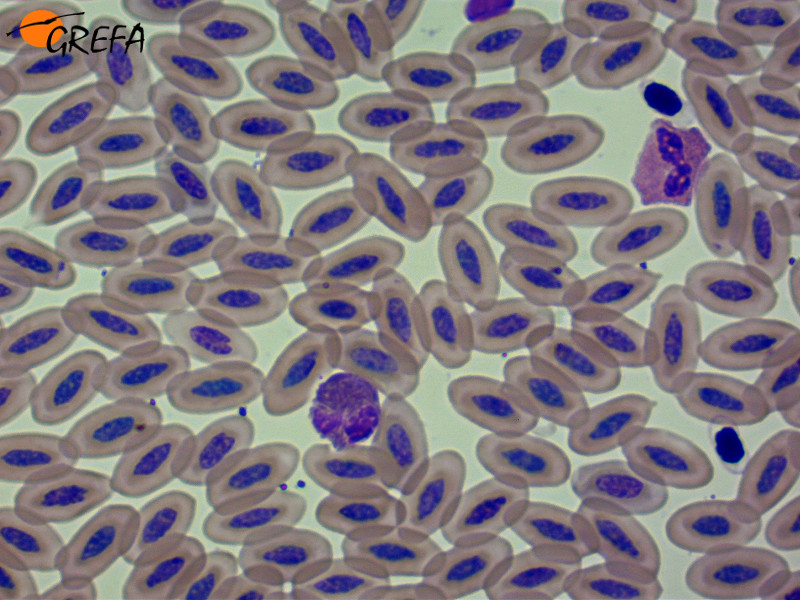
Hematología de águila imperial.

Los nuevos voluntarios del laboratorio de GREFA, durante el seminario de hematología.Tras varias semanas de entrenamiento, los nuevos voluntarios del laboratorio del Hospital de Fauna Salvaje de GREFA asistieron a un seminario sobre hematología en fauna silvestre, impartido por nuestra veterana Susana Torres. La formación constante de quienes dedican su tiempo a ayudarnos es una responsabilidad por la que apostamos fuerte para mejorar nuestra atención a los animales silvestres.
Durante este seminario se explicó tanto la utilidad como los protocolos de las técnicas que utilizamos, con el objetivo de que estos nuevos voluntarios afianzaran lo aprendido anteriormente y resolvieran todas las dudas que les hayan ido surgiendo, para poder así trabajar con mayor autonomía en el laboratorio. Tampoco se lo quisieron perder algunos voluntarios de otros departamentos del hospital de fauna de GREFA e incluso antiguos voluntarios que se dedican a clínica de animales exóticos.
La hematología es una rama del laboratorio que aporta muchísima información sobre el estado de los pacientes y que puede orientarnos e incluso confirmar el diagnóstico de multitud de patologías. Sin embargo, no es un trabajo sencillo…
Otra imagen de los voluntarios en el seminario de hematología.
Como todos sabéis, por nuestro hospital de fauna pasan muchas especies de aves, mamíferos y reptiles y cada una tiene sus características especiales. Por ejemplo, ¿sabíais que las aves y los reptiles tienen glóbulos rojos nucleados, mientras que los mamíferos no? Otro dato curioso: los glóbulos rojos generalmente tienen una vida media de 20-30 días en aves, mientras que en algunas especies de reptiles pueden llegar a ¡800 días!
Hematología de águila imperial. |
Hematología de zorro |